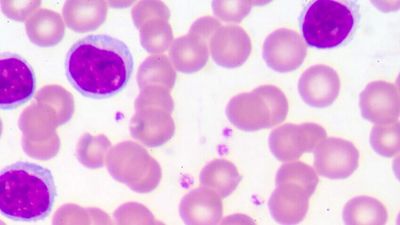

Poly Mva Treatment For Cancer
Poly mva treatment for cancer. We incorporate intravenous Poly-MVA as part of our foundational therapies for chronic fatigue detoxification Lyme disease and cancer management. Merrill Garnett in 1991 Poly-MVA MVA a proprietary mixture of minerals vitamins and amino acids was introduced in 1995. Poly-MVA is a compound promoted as a non-toxic alternative to chemotherapy to treat cancer particularly malignancies of the brain lung ovaries and breasts.
Surprisingly non-small cell lunge cancer is in general not a high responder to conventional treatments. Poly and Qunol CoQ10 with Pomegranate Juiceday and have noticed a substantial reduction of the tumor even at this minimal dose in conjunction with doTerra DDR Prime. Furthermore Poly-MVA is a highly-effective free radical scavenger yet it is more than that.
Angel Care Cancer Center has been studying Poly-MVA a liquid dietary supplement as an adjunct to cancer therapy since 2004. Taking Poly-MVA with Anti-oxidants Chelators Fiber and Steroids. Evidence-based through case reports.
Its ability to deliver electrons to the mitochondria is crucial in successfully treating cancer. 12000 22000. Poly-MVA Outcome-Based Investigation Conclusions Ø The top three cancers that were highly responsive to the Poly-MVA treatment were prostate breast and non-small cell lung cancer.
Poly-MVA also provides electrons which not only boost effectiveness of medical therapies such as chemotherapy and radiation but provides protection to cells while silencing cancer stem cells that mobilize during such therapies. Promoters claim that it boosts immunity reduces pain and enhances energy and appetite in. Since that occurrence and have recently developed another tumor which I am treating with 2 tsp.
IV Poly MVA as a Cancer Treatment. For over 20 years Poly MVA has been used as a safe treatment for cancer and chronic illnesses as well as for increasing the quality of life of patients on other cancer and chronic illness treatments 2. Poly-MVA for Pets can provide the following nutritional support to your pets body.
Poly-MVA protects and repairs damaged genes as a way of maintaining optimal metabolic cellular activity. The positive effects of Poly MVA are still being researched but for some Poly MVA has been a significant factor in reversing or preventing the progression of various types of.
Helps the body to produce energy Supports the liver Assists in preventing cell damage Assists it detoxification pathways Unique and Powerful antioxidant and detoxificant Supports nerve and neurotransmitter function Enhances various aspects blood cell function.
Promoters claim that it boosts immunity reduces pain and enhances energy and appetite in. Poly MVA is an effective safe and successful way to attack cancer. Angel Care Cancer Center has been studying Poly-MVA a liquid dietary supplement as an adjunct to cancer therapy since 2004. Its ability to deliver electrons to the mitochondria is crucial in successfully treating cancer. AMARC does not sell medicines or supplements which are intended to diagnose treat cure. Safe for children 2. Colorectal cancers were the least responsive. Helps the body to produce energy Supports the liver Assists in preventing cell damage Assists it detoxification pathways Unique and Powerful antioxidant and detoxificant Supports nerve and neurotransmitter function Enhances various aspects blood cell function. Merrill Garnett in 1991 Poly-MVA MVA a proprietary mixture of minerals vitamins and amino acids was introduced in 1995.
Poly and Qunol CoQ10 with Pomegranate Juiceday and have noticed a substantial reduction of the tumor even at this minimal dose in conjunction with doTerra DDR Prime. Poly-MVA has shown to assist and facilitate this process. Taking Poly-MVA with Anti-oxidants Chelators Fiber and Steroids. Safe for children 2. Helps the body to produce energy Supports the liver Assists in preventing cell damage Assists it detoxification pathways Unique and Powerful antioxidant and detoxificant Supports nerve and neurotransmitter function Enhances various aspects blood cell function. Poly-MVA is a proprietary formulation that contains palladium alpha-lipoic acid thiamine riboflavin cyanocobalamin formyl-methionine and N-acetylcysteine. Merrill Garnett in 1991 Poly-MVA MVA a proprietary mixture of minerals vitamins and amino acids was introduced in 1995.

Posting Komentar untuk "Poly Mva Treatment For Cancer"